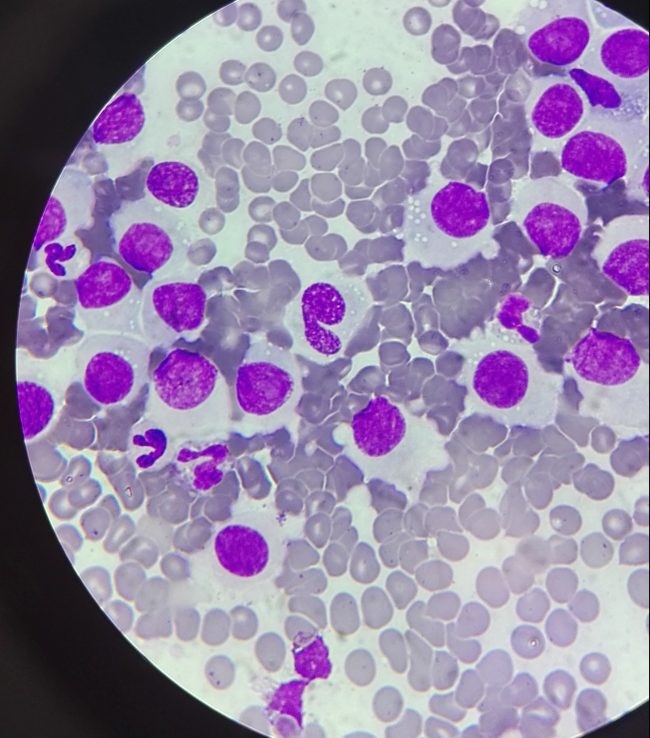

Tumor Venéreo Trasmisible Canino
LUNA es una preciosa perrita mestiza de aproximadamente dos años, que fue rescatada de la calle junto a sus cachorritos. A los tres meses tras el rescate observaron que Luna había comenzado a presentar un sangrado intermitente, además de unas protuberancias en la zona vulvar.
 Durante la exploración en ambos labios vulvares presentaba unas masas de consistencia firme. Realizamos una citología en la que se apreciaron células redondeadas con el citoplasma vacuolizado y un alto índice mitótico, sospechando de una neoplasia en el tracto reproductivo muy frecuente en nuestro país.
Durante la exploración en ambos labios vulvares presentaba unas masas de consistencia firme. Realizamos una citología en la que se apreciaron células redondeadas con el citoplasma vacuolizado y un alto índice mitótico, sospechando de una neoplasia en el tracto reproductivo muy frecuente en nuestro país.

Tras la evaluación clínica confirmamos que Luna presentaba un Tumor Venéreo Transmisible (TVT) o Tumor de Sticker. Se trata de un tipo de sarcoma, que a diferencia de otros tumores se trasmite de individuo a individuo principalmente por vía venérea. Este tipo de tumor es muy frecuente en nuestro país debido a que la población de colonias de perros callejeros es muy elevada, en comparación con otros Países.
El periodo de incubación y desarrollo del tumor fluctúa entre los 2 y 6 meses tras la monta, y comienzan a aparecer pequeñas tumefacciones que van creciendo y extendiéndose por toda la zona perineal y escrotal, pudiendo invadir el recto y metastatizar a otras vísceras como bazo e hígado. La citología de dichas tumefacciones da lugar a agrupaciones de células de gran tamaño con grandes núcleos, citoplasmas escasos con presencias de vacuolas en su interior e índices mitóticos elevados. Los signos clínicos varían entre los machos y las hembras, presentando estás últimas tumefacciones visibles en la zona vulvar, sangrados esporádicos que pueden ser confundidos por el estro pero que duran más de lo normal. En machos es característico detectar la tumefacción en la zona peneana, con pérdidas sanguinolentas continuas y en ocasiones disuria (por la oclusión del tumor en la uretra peneana). Además de la presentación genital, el Sarcoma de Sticker presenta un desarrollo extragenital que puede afectar a la cavidad intranasal y oral (labios y lengua), ojo (esclerótica y cámara anterior) y piel.
El tratamiento se realiza con quimioterapia con una reducción efectiva del 90 al 95% de los casos, en comparación con una resolución quirúrgica en la que la tasa de recidiva es de un 20 a un 60% de los casos. El quimioterápico utilizado es la Vincristina a 0,5-1 mg/metro cuadrado, de forma endovenosa una vez por semana durante 4-6 semanas, recomendándose por seguridad, continuar con la pauta durante 2 semanas más tras la remisión del cuadro. Antes de comenzar con el tratamiento es recomendable realizar una exploración física completa además de un hemograma completo que deberíamos repetir antes de la tercera aplicación, ya que dentro de los efectos secundarios de la Vincristina encontramos vómitos, neuritis, leucopenia y depresión de la médula ósea.
El tumor es curable en un porcentaje mayor al 95% de los casos
¡Luna ya ha finalizado con su protocolo quimioterápico de Vincirstina, el tumor ha remitido de forma completa y ahora Luna está Sana y Feliz! 

Dra Sigrid de Paz


